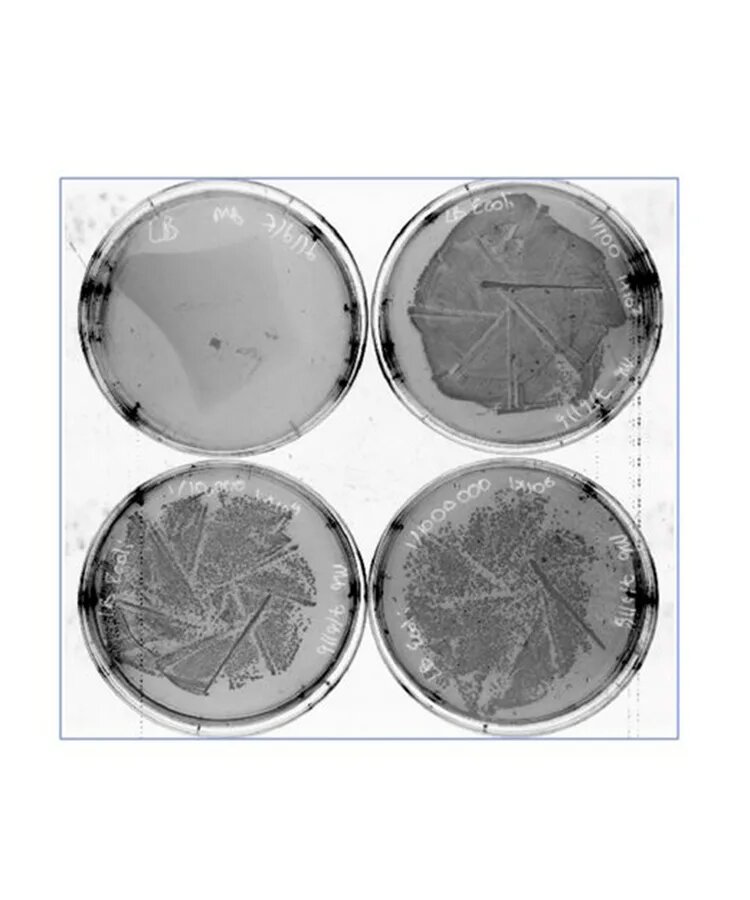

SINGKAWANG-Semarak Malam Pawai Lampion 2026 di Kota Singkawang, Meriah Diramaikan Ribuan Penonton
Pancasila sebagai Dasar Negara dan Pedoman Hidup Bangsa Indonesia SINGKAWANG-Semarak Malam Pawai Lampion 2026 di Kota Singkawang, Meriah Diramaikan Ribuan Penonton PAWAI LAMPION – Ribuan masyarakat tumpah ruah di sekitaran